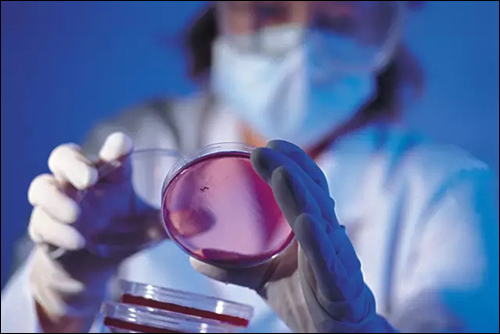
640

众所周知,传统塑料制品需要消耗大量石油,是碳排放超标的主要因素之一,造成的“白色污染”遗祸无穷。2017年两会上,全国人大代表、江南大学副校长金征宇在接受记者采访时表示,如果推进食品包装塑料制品绿色化,采用生物基材料替代塑料制品,就能够有效治理“白色污染”,改变我国在气候变化问题上的被动局面,并为全球解决日益严重的能源和环境问题做出贡献。
“随着我国食品包装市场、餐饮流通物的发展,食品预包装的要求和需求都在不断的攀升,同时,食品包装对于塑料制品的需求量也在不断攀升,”金征宇代表指出,“我国目前聚丙烯和聚乙烯的自给率不足,只能达到80%,还有20%是依赖于进口,而这些塑料制品,特别是与食品接触的一次性塑料制品的石油基材料不要求耐久性,短时间使用后就会被大量废弃,造成了更加严重的白色污染。”
从上述内容来看,生物基材料的开发利用可谓上合国策,下顺民心。小编搜集了国内外100+生物基材料相关的企业,供大家参考,喜欢的话记得点点关注,分享一下哦!
一、 国外代表(排名不分先后)
1、美国Natureworks公司
主要产品:PLA
应用领域:包装matchmatch材料、纤维和非织造物等,服装(内衣、外衣)、产业(建match筑、农业、林业、造纸)和医疗卫生等。
2、德国的因维塔弗希尔(Inventa-Fischer)公司
主要产品:PLAmatch
应用领域:包装材料match、纤维和非织造物等
3、瑞士苏尔寿(Sulzer)
主要产品:PLA
应用领域:医疗卫生、服装纺织。
4、日本帝人(Teijin)
主要产品:PLA
应用领域:医疗卫生、服装纺织。
5、柯碧恩-普拉克(Corbion Purac)
主要产品:乳酸及衍生物,聚乳酸(PLA)
应用领域:食品包装、医药、服装。
6、Bio Amber公司
主要产品:丁二酸
7、应用碳化学公司(Applied Carbochemicals)
主要产品:丁二酸
8、Arkenol公司
主要产品:丁二酸
9、Cereplast
主要产品:PLA、PHA及其复合材料
10、Genomatica公司
主要产品:丁二酸及其衍生物
11、德国赢创
主要产品:生物基 BDO 催化剂、生物质纤维素、柠檬酸、酒石酸等。
12、阿克玛Akima
主要产品:生物基尼龙
13、巴斯夫BASF
主要产品:BIO、PBS、PLA、 生物尼龙等。
14、帝斯曼DSM
主要产品:PHA等。
15、陶氏杜邦
主要产品:生物PE、PTT纤维、生物基PA等。
16、Rennovia公司
主要产品:生物基PA等。
17、AEP Polymers
主要产品:生物基高分子材料(多元醇、胶黏剂等)。
18、三菱化学
主要产品:生物基尼龙
19、Covestro 科思创
主要产品:生物基热塑性聚氨酯等。
20、Cargill
主要产品:PBS、PLA
21、Danimer
主要产品:丁二酸、PHA
22、Myriant Technologies
主要产品:PBS
23、PHB Industrial
主要产品:PHB、PHA
24、Pyramid Plastics
主要产品:PLA
25、Biomer
主要产品:PHB
26、Kaneka
主要产品:PHA、PLA
27、JSR Corp.
主要产品:PLA
28、Toray
主要产品:PLA、PET等
29、FKuR
主要产品:PLA
30、Solvay
主要产品:Zeniva牌PEEK(聚醚醚铜)、Proniva增强型聚亚苯基、Veriva牌及Eviva牌PSF(聚砜)等热塑性生物材料。
二、 国内代表(排名不分先后)
1、浙江海正生物材料股份有限公司
由浙江海正集团有限公司、中科院长春应用化学研究所、台州市椒江区国有资产经营有限公司等于2004年8月共同出资组建。开创了中国聚乳酸材料产业化生产的新局面,是中国首家聚乳酸产业化生产企业,也是全球首家耐高温聚乳酸产业化生产企业。2006年底,海正生物材料第一条年产5000吨的生产线正式投入生产。
主要产品:聚乳酸(PLA)
应用领域:一次性制品、文具领域、纤维领域、3D打印耗材、膜类用品、婴童用品、家具日用品
2、江苏允友成生物环保材料有限公司
于2012年4月投资组建,占地150亩,总投资超过12亿人民币,被列为江苏省重大产业项目,在10年内产量产能预估将达16万吨。
主要产品:聚乳酸(PLA)
应用领域:汽车内饰、食品、电子、日用品、五金制造等多种产品的绿色包装,3D打印耗材,奶瓶、化妆品瓶,饮料瓶等注吹成型工艺等。
3、江苏仪征化纤纺织有限公司
主要产品:聚乳酸纤维
应用领域:服装行业
4、南通九鼎生物工程有限公司
主要产品:聚乳酸
应用领域:复合材料、生物医用材料等。
5、同杰良生物材料有限公司
同杰良公司成立于2005年,由自然人、上海创业投资有限公司、上海杨浦科技投资发展有限公司、上海同济大学科技园有限公司、上海同济新产业发展公司、研发及管理团队共同出资组建,是一家专业从事生物材料、化工、环保等领域的技术开发、技术转让、技术咨询和技术服务的高科技企业。
主要产品:聚乳酸纤维、切片、无纺布
应用领域:服装、医用、农用地膜、包装材料等。
6、深圳光华伟业股份有限公司
深圳光华伟业股份有限公司成立于2002年,以绿色为主题,致力于环境友好型材料的产业化,专门从事生物材料、绿色溶剂的研究开发、生产经营,是国家级高新技术企业,是国家战略性新兴产业新材料项目承担单位,公司于2016年4月5在新三板挂牌成功。目前已建成年产聚合物10000吨,乳酸酯15000吨,多元醇5000吨,3D打印材料1500吨的生产能力。
主要产品:聚乳酸、聚己内酯、乳酸脂、多元醇
应用领域:3D打印、热熔胶、复合纤维等。
7、吉林中粮生化有限公司
隶属中粮集团。
主要产品:聚乳酸等。
应用领域:快速消费品包装材料、塑料袋等。
8、山东金玉米生化有限公司
主要从事淀粉及其深加工技术。
主要产品:聚乳酸
9、江苏天仁生物材料有限公司
江苏天仁生物材料有限公司创建于2010年8月,是一家致力于生物基可降解高分子材料的研发、生产和销售为一体的专业型公司。公司现有河南天仁生物材料研究所、河南龙都天仁生物材料有限公司、河南青源天仁生物科技有限公司三家子公司,并于江苏南通、镇江、河南建有生产基地。
主要产品:全生物降解改性树脂、各种类型购物袋、垃圾袋,全生物降解地膜,育苗盘,汽车用纤维材料,全降解纸杯、餐具等产品。
应用领域:塑料袋、保鲜膜、手提袋、水杯、汽车等。
10、浙江台州邦丰塑料有限公司
公司技术人员利用二氧化碳和环氧化物在催化剂的作用下,共聚可得到交替型脂肪族聚碳酸脂,这种聚合物具有良好的环境可降解性。与中科院合作投资在温岭上马工业区,一期投资2.3亿,年产3万吨可降解塑料,年产二乙基锌300吨,产值6亿元,纳税7000万,二期年产10万吨可降解塑料,年产二乙基锌600吨,产值20亿。
主要产品:二氧化碳基降解塑料
主要用途:一次性餐具,塑料袋,水杯等。
11、河南天冠集团有限公司
天冠集团是中国生物能源产业的开拓者和先行者,早期开发了燃料乙醇、二氧化碳基塑料等。公司在职员工6500余人,资产120亿元,占地7200余亩,拥有国内最大的年产80万吨燃料乙醇和18万吨优质食用酒精生产能力,建成了国际上最大的日产50万m3生物天然气工程、年产7.5万吨谷朊粉生产线和国际领先的5万吨级纤维乙醇产业化示范装置、万吨级全降解塑料(PPC)装置以及万吨级生物柴油装置,同时在柬埔寨和东南亚拥有面积超过10万公顷的非粮原料基地。下属公司南阳中聚天冠低碳科技有限公司
主要产品:生物燃料、二氧化碳基塑料
主要用途:普通吹膜料、地膜料、阻隔包装材料、塑料袋等。
12、江苏中科金龙化工股份有限公司
世界上最早拥有万吨级CO2基树脂生产线及其完整的、原创性的知识产权,包括催化剂制备,聚合工艺,反应(生产)装置等15项中国发明专利。
主要产品:聚碳酸亚丙酯多元醇、聚碳酸亚丙酯基水性聚氨酯乳液、CO2基阻燃保温材料、全生物降解材料、高分子共聚生物材料。
应用领域:聚氨酯弹性体、涂料、油漆、粘合剂、聚氨酯泡沫塑料、缓冲包装材料、外墙保温阻燃建筑材料、塑料包装膜等广泛领域的应用。
13、江苏南通华盛新材料公司
南通华盛新材料股份有限公司,地处长江三角洲沿海地区中部,江苏省南通市通州区,厂区占地面积10万平方米,主要从事聚乙烯薄膜製品和生物降解膜的技术研发。
主要产品:各类购物袋、食品袋、垃圾袋、服装袋、多层共挤膜、工业包装膜、抗菌抗静电膜、生物降解膜及制品等。
应用领域:快速消费品包装,购物袋等。
14、吉林金源北方科技发展有限公司
吉林金源北方科技发展有限公司于2004年12月,由冯超研究员、吉林大学等共同投资设立,落户吉林大学国家科技园,是一个产、学、研密切结合,科研、中试、生产自成体系,从事新材料科技成果转化的高技术企业。公司注册资金3400万元人民币,占地2万平方米,一期建成厂房、实验室1.1万平方米。
主要产品:二氧化碳聚合物
应用领域:口腔科可降解生物诱导膜、二氧化碳可降解骨科材料、可吸收缝合线、生物诱导膜、医用敷料、可降解注射器、药泡罩、塑料袋等。
15、宁波天安生物材料有限公司
宁波天安生物材料有限公司是国内第一家采用生物发酵工程技术,将完全生物降解材料实现产业化的高新技术企业。公司生产的PHBV(β-羟基丁酸与戊酸酯共聚物)是一种天然的高分子材料,也是国际上公认的具有100%生物分解能力的材料。
主要产品:PHBV
应用领域:医用材料(缝线、骨钉)、薄膜材料(地膜、购物袋、堆肥袋)、一次性用品(笔、餐具)、包装材料(特别是食品包装)等。
16、天津国韵生物材料有限公司
国韵生物开发的PHA系列产品(商品名:绿素SoGreen)是一种可完全生物降解的生物基高分子材料,其制品用完废弃后无需堆肥,于土壤、污水、河水、海水中经3~6个月可被微生物分解成CO2和水,是国际公认的具有生物分解能力的聚合物材料。公司具有年产万吨PHA的生产能力,且具有雄厚的下游应用领域研发实力。
主要产品:PHA发泡粒料、树脂原料、吹膜粒料等。
应用领域:全降解发泡餐盒、塑料袋等。
17、武汉华丽生物材料有限公司
公司一直致力于“PSM?”非粮热塑淀粉、PLA聚乳酸等天然生物基材料的改性、研发及制品的生产和推广。
主要产品:生物基复合材料、健康环保家居日用品、生物塑料包装。
应用领域:环保膜类制品、生物质餐饮具、酒店用品、厨房用具、健康环保玩具、花卉包装用品等。
18、广东益德环保科技有限公司
广东益德环保科技有限公司是集科研、设计、制造、销售一体的高新技术企业。企业的主要设备“淀粉降解材料挤出片材机组”系“国家重点新产品”和“国家级火炬计划项目”,其技术处于国内领先,达到国际领先水平。
主要产品:可完全生物降解的生态环保、材料、膜类及其制品。
应用领域:包装行业、餐饮业、药品行业、温室育苗盆、农用膜等。
19、苏州汉丰新材料股份有限公司
专业从事生物基与生物降解材料及制品,集种植、研发、生产、销售于一体的国家高新技术企业,隶属于中城联合投资集团,公司建有“苏州市生物基与生物分解材料工程技术研究中心”,全资拥有年产3.5万吨的木薯淀粉及其变性淀粉子公司,广泛开展产学研合作,承担了各级各类科技开发项目,形成了独有的从木薯淀粉、变性淀粉到生物基与生物分解材料及制品的技术、产品和产业链。
主要产品:原料、餐具系列、膜袋等。
应用领域:餐饮领域等。
20、浙江天禾生态科技有限公司
浙江天禾生态科技有限公司系中外合资企业,是一家以研究、生产、销售生物基全分解母粒、生物基全分解片材及生物基全分解膜袋制品的生态环保型高新技术企业。
主要产品:托盘、水杯、塑料勺子等。
应用领域:餐饮领域
21、浙江华发生态科技有限公司
浙江华发生态科技有限公司是一家专业研究、生产、销售生物基降解材料及制品的高新技术企业,目前投资1.2亿元,已建成年产10000吨生物基降解材料和5000吨绿色软体包装产品现代化生产线。开发的生物基降解材料达到国际先进水平。
主要产品:生物降解材料、制品(刀叉勺、餐盒、杯碗等)、绿色膜胶等。
应用领域:一次性医疗用具、电子、化妆品、保健品、玩具、礼品等内托产品,高档一次性餐饮具,各种软体降解膜胶袋、食品包装膜等。
22、比澳格(南京)环保材料有限公司
比澳格集团是澳大利亚知名企业,从事生物降解塑料行业多年,拥有先进的技术和广泛的国际市场。目前已在中国香港和南京投入巨资成立香港比澳格公司和比澳格(南京)环保材料有限公司。
主要产品:可降解树脂,环保型塑料袋、堆肥类全生物降解袋、光降解袋等。
应用领域:餐饮包装等。
23、广东上九生物降解塑料有限公司
广东上九生物降解塑料有限公司于1999年12月成立,位于广东省制造业名城的东莞市,注册资金人民币3000万元,主要从事研究、生产和销售生物降解塑料的专业公司。经十多年的努力,获得多项国家发明专利和国际专利,成功开发了低成本的淀粉基全生物降解塑料和可生物降解塑料等系列产品,产品已经通过ASTM D6400, EN13432, ISO16929,ISO14855等标准检测和相关认证,并取得多个国家安全环保认证及进口许可证。
主要产品:薄膜类降解塑料、注塑类降解塑料、片材类降解塑料和发泡类降解塑料等。
应用领域:包装领域、旅游用品、一次性塑料杯等。
24、烟台阳光澳洲环保材料有限公司
烟台阳光澳洲环保材料有限公司为中国国内规模最大的淀粉基生物降解环保材料生产企业之一。现为中国降解塑料委员会副会长单位。公司致力于环保科技产业的发展,采用独家专有、国内领先的淀粉基生物降解材料技术工艺和整套全自动流水作业生产设备,专业生产各类淀粉基新型环保生物降解食品包装及工业包装产品。在国内同行业中首家实现了全过程封闭式、无菌、无尘化生产。产品的安全性、耐高、低温性能、降解性能等各项指标均符合中国国家标准GB-18006.1的要求。
主要产品:食品包装、碗碟、杯子、盘子、盒子等。
应用领域:食品包装、餐饮行业。
25、常州龙骏天纯环保科技有限公司
常州龙骏天纯环保科技有限公司是一家致力于新型绿色环保高分子材料领域,集技术研发、规模化生产和市场营销为一体的专业化公司。公司目前拥有生物基生物降解材料生产线6条,设备数量30台套以上。年可生产生物基生物降解材料10000吨以上,生物基生物降解餐饮具及食品包装制品1亿只以上,是国内生物基生物降解材料及制品的重要生产企业。
主要产品:生物基可降解材料及制品专用成套设备,包括积木式平行双螺杆挤出造粒机组、积木式平行双螺杆挤出片材机组、全自动变频式高速混合机组、全伺服自动正负压成型机等专用设备。
应用领域:食品包装等。
26、肇庆市华芳降解塑料有限公司
肇庆市华芳降解塑料有限公司于2004年05月24日在肇庆工商局注册成立,注册资本为180万元,目前是肇庆塑料制品业黄页行业内知名企业。
主要产品:完全生物降解塑料及母粒。
应用领域:包装袋、购物袋等。
27、深圳虹彩新材料科技有限公司
虹彩科技,包含深圳市虹彩新材料科技有限公司与嘉兴彩联新材料科技有限公司两家企业,由深交所上市企业彩虹精化于2012年10月份同期全资兴建,立志打造世界领先的提供生物降解塑料改性材料与制品研发与生产一体化解决方案的现代化高科技企业。
主要产品:冰激凌勺、水杯、医用一次用品、吸塑类-餐具、牙刷、梳子、吹膜母粒、吸塑制品、注塑制品、膜袋制品等。
应用领域:医疗、酒店用品、餐饮包装等。
28、普宁市华芝路生物材料有限公司
华芝路公司是一家生物基分解塑料专业化研发、生产和销售为一体的综合性高新技术企业。华芝路公司拥有世界领先的生物基分解树脂的生产工艺及改性技术、最先进的生物基塑料生产线、最为齐全的环保塑料制品袋膜等生产线。公司所生产的生物基分解塑料及制品的各项性能指标完全符合并超国家及行业相关标准,以可靠稳定的品质及具有竞争力的价格成为全球生物基分解塑料及制品主要供应商。
主要产品:
原材料:完全生物降解树脂、完全生物降解注塑树脂、淀粉基可生物降解树脂(添加型)、淀粉基生物分解专用树脂、淀粉基可生物降解注塑树脂等系列树脂材料。
制品:完全生物降解制品袋(环保购物袋、环保包装袋、环保垃圾袋等);淀粉基可生物降解制品袋(首创淀粉基保鲜袋、高淀粉含量分类垃圾袋、环保购物袋、淀粉基生物降解手套等等)。其中,首创淀粉基保鲜袋的生物含量高至51%以上,厚度薄至0.006mm;高淀粉含量分类垃圾袋的生物含量达51%以上;淀粉基生物降解手套的生物含量大于50%等。
应用领域:购物袋、保鲜膜等。
29、山东必可成环保实业有限公司
山东必可成环保实业有限公司生产全降解原料及制品,产品分4大类,产品品种近100种。该产品置于堆肥环境下90天内可全部降解为水和二氧化碳,对环境不会带来任何污染。产品已于2008年通过美国ASTM6400、欧盟EN13432、澳大利亚AS4736等国际标准认证,目前全部出口到澳大利亚、英国、意大利、美国等国家。
主要产品:玉米降解购物袋、玉米降解原料、玉米降解托盘、玉米降解餐盒、生物降解购物袋、生物降解水杯、生物降解原料等。
应用领域:餐饮行业、食品包装
30、江苏锦禾高新科技股份有限公司
江苏锦禾高新科技股份有限公司成立于2011年,位于江苏省扬州市,注册资金3000万元,致力于生物质新材料的关键技术和共性技术的工程化研究,运用生物材料复合改性技术,以农业再生资源为主要原料,如淀粉、秸秆、稻壳等,研发、生产及销售生物质环保新材料。目前公司已掌握了从原材料研发到制品生产各个环节的核心技术,尤其是秸秆改性塑化技术已达到国内领先水平。公司现已具备年产3万吨生物质塑料的生产规模。
主要产品:秸秆生物塑料、淀粉基生物塑料、淀粉基膜袋、秸秆3D
应用领域:购物袋等。
31、四川(五粮液集团)普什集团
普什“高分子原料及深加工”产业由普拉斯包装材料有限公司、四川普什醋酸纤维素有限责任公司、普什建材有限责任公司等公司构成。集研发、设计、加工制造于一体,拥有从高分子原料及深加工产品到各类包材、建材的完善制造和服务体系,已逐步发展成为行业生产的领先者。该产业提供的醋酸纤维素产品、聚酯切片、聚酯瓶坯、聚酯瓶、三维立体防伪包装、光栅 光面片材、立体影像及广告、瓶盖、托盘、周转箱、礼品袋、烤标瓶、热缩膜、镭射膜、医药塑料包装及管材、管件等产品,其产品与服务遍及世界各地,并具有满足客户多种要求的研发、定制生产能力,正迅速成为行业领军企业。
主要产品:醋酸纤维素产品、聚酯切片、聚酯瓶坯、聚酯瓶、三维立体防伪包装、光栅 光面片材、立体影像及广告、瓶盖、托盘、周转箱、礼品袋、烤标瓶、热缩膜、镭射膜、医药塑料包装及管材、管件等产品。
应用领域:医用、酒品包装等。
32、合肥恒鑫环保科技有限公司
合肥恒鑫环保科技有限公司,是一家致力于环保产品研发、生产、销售与一体的现代化高科技企业,是中国聚乳酸(PLA)制品规模化生产企业的典范,在全球PLA快消产品市场占有重要的地位。下辖安徽恒鑫环保新材料有限公司、吉林恒鑫环保科技有限公司和吉林中粮生物材料有限公司(合资公司)、上海川鼎水处理(控股公司)。产品线覆盖PLA原料到制成品全产业链及水处理。
主要产品:聚乳酸原料和聚乳酸制品、包括纸杯及各类PLA杯盖、刀、叉、勺、吸管、搅拌棒、发泡餐具、食品包装容器等配套产品。
应用领域:餐饮、食品包装等。
33、厦门协和环保科技有限公司
厦门协和环保科技有限公司成立于2006年11月。经过多年的发展,已经成为中国国内领先的集绿色环保食品包装材料以及制品的研发、生产和销售一体化的综合性企业。厦门协和环保科技有限公司是香港愉富国际发展有限公司的全资子公司。
主要产品:聚乳酸食品包装材料、餐具等。
应用领域:餐饮、食品包装等。
34、苏州翰普高分子材料有限公司
生物基尼龙树脂、尼龙610、尼龙612、尼龙11
主要产品:尼龙610,612、汽车油管、刹车管尼龙专用料、电池密封圈专用料等。
应用领域:电缆、钢索涂层、单丝生产、管材等。
35、上海凯赛生物技术研发中心有限公司
2003年以来,凯赛生物科技一直是一家开创性的工业生物技术公司,拥有商业化的生产规模,长链二元酸生产拥有世界领先的地位,该产品主要用于尼龙,聚酯,粘合剂和生物溶剂。凯赛尖端的技术创新让生产源自可再生原料的化工品和燃料成为可能。
主要产品:六种长链二元酸、聚酐(C-Shield)、混合酸(PureMix)和混合酸2代(PureMix II)
应用领域:高性能聚酰胺/尼龙、芳香剂、粉末涂料、防锈剂、润滑油、粘合剂、制药等。
36、山东拓普生物材料有限公司
山东拓普生物材料有限公司成立于2014年3月,是一家致力于研发、生产生物制品,以及尼龙新材料产品的高科技股份制营企业。公司目前正在建设符合国家产业政策、附加值高的生物新材料项目。项目占地1000亩,计划建设3万吨/年生物单体及1万吨/年尼龙新材料。项目建成后可实现年销售收入15亿元,利税3亿元以上。
主要产品:长碳链二元酸、尼龙新材料。
37、海宁新能纺织有限公司
海宁新能纺织有限公司成立于2005年,是香港查氏集团和美国纤维技术发展有限公司(FIT)在中国设立的生产基地之一,主要从事各种高性能、功能化和差别化纤维的生产和销售。
主要产品:PLA 纤维、PPS纤维、ES纤维等。
应用领域:纺织服装领域等。
38、张家港市安顺科技发展有限公司
公司是中国最早的涤纶短纤生产厂家之一,也是张家港最大涤纶短纤厂家。主要产品有各种规格涤纶短纤、纺晴纶差别短纤维、有色纤维、功能纤维。
主要产品:生物基纤维、涤纶短纤、PET原料等。
应用领域:纺织服装等。
39、中国石化仪征化纤股份有限公司
仪化有限公司主要从事聚酯和涤纶纤维的生产及销售。目前拥有2套PTA生产装置,产能100万吨/年;16条聚酯生产线,聚酯聚合能力220万吨/年;34条涤纶短纤维(中空)生产线,产能80万吨/年;5条瓶级切片生产线,产能45万吨/年;2套超高分子量聚乙烯纤维干法纺丝装置,产能1300吨/年;1套对位芳纶试验装置,产能100吨/年;1套1,4-丁二醇(BDO)装置,产能10万吨/年;以及配套水、电、气、汽等公用工程。
主要产品:PBT纤维等。
应用领域:纺织服装等。
40、无锡市兴盛新材料科技有限公司
无锡市兴盛新材料科技有限公司是PBT工程塑料及PBT长丝的重要生产基地,总投资约10亿元。公司引进两条先进的PBT聚合生产装置,分期建成8万吨×2条的PBT聚合及弹性纤维生产线,同时配套2条切片复合纺及苏巴加弹(带零罗拉)设备,满足高品质客户个性化需求。
公司PBT弹性纤维生产线是世界上首条连续聚合熔体直接纺工艺生产线。与切片纺工艺相比,直接纺工艺流程短,单位产品生产成本低。特别是直纺工艺提高了纺丝熔体的质量稳定性,有利于连续生产高品质的产品。
在发展PBT系列产品基础上, 公司实施多元化发展战略,同时开发生产尼龙一66、氨纶等高性能纤维产品。该项目属于国家鼓励发展的高新技术范畴,是国家“十二五”规划重点发展的高新产品。
主要产品:PBT纤维等。
应用领域:纺织服装领域等。
41、南通盛虹高分子材料有限公司
主要涉及塑料、橡胶、纤维及原料、危险化学品批发(不带仓储)、玻璃制品及原料、纺织品及纺织原料(除专营),服装及面辅料,五金机电、包装材料的销售。(依法须经批准的项目,经相关部门批准后方可开展经营活动)。
主要产品:PBT纤维
应用领域:纺织服装等。
42、保定天鹅化纤集团有限公司
保定天鹅新型纤维制造有限公司积极推进产品转型升级,已成功建设并运行莱赛尔纤维生产线,成为世界上第二家、国内第一家莱赛尔纤维制造商。2015年成功推出莱赛尔纤维高端品牌——“元丝”,莱赛尔纤维原料来自林业、农业的天然纤维素,采用清洁、环保、可回收的溶剂,整个生产系统形成闭环回收再循环系统,没有废物排放,可以自然降解,不存在二次污染,被誉为21世纪绿色纤维。
保定天鹅莱赛尔项目的建设对我国粘胶纤维产业的转型升级、实现再生纤维素纤维的结构调整具有重要推动作用,同时也将打破溶剂法纤维素纤维的国际垄断,提高公司在新型纤维素纤维领域的竞争力。
主要产品:莱赛尔(lyocell)纤维等。
应用领域:纺织服装
43、上海里奥纤维企业发展有限公司
上海里奥纤维企业发展有限公司是上海市科教兴市产业化攻关项目,所生产的高新技术产品--ALICELL和KINGCELL,是国内第一家产业化LYOCELL纤维的制造厂家。公司是由中国高新投资集团公司、上海大盛资产有限公司、上海纺织控股(集团)公司和上海化学纤维(集团)有限公司投资组建的,年产1000吨LYOCELL纤维生产装置于2006年底投入运行。
主要产品:莱赛尔(lyocell)纤维等。
应用领域:纺织服装等。
44、中纺院绿色纤维股份公司
主要产品:莱赛尔(lyocell)纤维等。
应用领域:纺织服装等。
45、中鲈科技发展股份有限公司
江苏中鲈科技发展股份有限公司注册资本10000万元,占地580亩。公司引进国际、国内先进设备,实施高科技产品发展战略,集研发、设计、生产于一体,迅速形成了国内首屈一指的化纤高科技产品研发与生产基地,取得了大量的国内、国际领先产品与技术。公司于2008年7月建成投产世界上首条PTT纤维专业化生产设备,该装置按照PTT纤维本身的特性进行设计,通过与德国巴马格公司合作进行集成创新,各单元设计充分考虑PTT纤维不同于常规涤纶纤维的物理化学特性,在设备和工艺方面进行创新,获得良好的综合质量效果。产品质量迅速达到世界先进水平,迅速占领国内市场,目前已经形成了具有2万吨/年PTT纤维生产能力,成为行业龙头企业。并作为第一起草人撰写了PTT纤维的3项行业标准。
主要产品:PTT切片、全消光切片、全消光系列纤维、PTT纤维系列、PET色丝系列。
应用领域:纺织服装
46、山东英利实业有限公司
英利实业创建于2010年,是一家集绿色纤维及制品开发、生产、销售为一体的科技型企业,注册资金2亿元。下设山东英利实业有限公司、山东嘉成赛尔新材料有限公司、英利配套供热中心、上海英利进出口有限公司等多家分公司。
公司以绿色环保Lyocell纤维产品开发为主体,积极协助高端客户开发色纺纱、多纤混纺纱、色纺面料、提花面料、高档医卫材料以及生态、健康、时尚、功能性的服装、家纺等高附加值产品,为众多客户提供一流的溶剂法纤维素纤维产品。
主要产品:Lyocell纤维
应用领域:纺织服装
47、厦门百美特生物材料科技有限公司
厦门百美特生物材料科技有限公司是面膜布、面膜和医用藻酸盐高级伤口敷料等产品专业生产加工的公司,拥有完整、科学的质量管理体系。
主要产品:海藻抗菌服饰、面膜纸、创口贴等。
应用领域:纺织服装、医疗卫生等。
48、青岛康通海洋纤维有限公司
公司是青岛大学为实现863重点项目产业化而成立的股份制有限公司,成立于2012年1月,是高新技术企业,主要从事研发、生产和销售海洋纤维、海洋材料、阻燃纤维材料、功能纺织品、海洋纺织品等。
主要产品:海洋纤维、海洋材料、阻燃纤维材料、功能纺织品、海洋纺织品等。
应用领域:军用、消防用、高档酒店用纤维服装。
49、海斯摩尔生物科技有限公司
海斯摩尔生物科技有限公司是一家集生物新材料及其制品的研究、开发、测试、生产、加工、销售为一体的高科技企业。公司拥有纯壳聚糖纤维生产的全套关键技术,是全球最大的海洋生物再生纤维(海斯摩尔)综合研发基地,技术国际领先,装备世界首创,产能全球最大,拥有中科院理化所抑菌检测中心泰安分中心、山东多糖生物质纤维工程实验室,拥有各种高精尖实验设备。
主要产品:壳聚糖纤维(医疗器械、面膜、袜品、内衣、家居、卫生巾)。
应用领域;:面料领域、医疗领域、卫生领域、航天领域、军品领域、过滤防护领域。
50、天津中盛生物工程有限公司
天津中盛生物工程有限公司位于天津滨海新区,是一家集生物元甲壳胺纤维和海藻酸纤维及医疗用品研发、生产、销售、服务于一体的高新生物技术企业。公司利用具有国际先进水平的生物技术,研发、生产纯天然抗菌保健生态纤维——生物元甲壳胺纤维。公司拥有在新型生态纤维研究和应用开发领域卓有声望的高级专家及在纺织领域、医用敷料、市场营销领域国内一流的专家团队,拥有从基础原料到产品市场化的全程生产技术和运作经验。
主要产品:生物元甲壳胺纤维、复合面料、功能面料、敷料、护创材料、毛巾、袜子、浴巾、沙滩巾功能纤维、无纺布/非织造布、化纤纱线。
应用领域:纺织领域、医用敷料等。
51、绍兴绿斯达新材料有限公司
绍兴绿斯达新材料有限公司致力于创新型功能生物塑料材料的研究开发以及这些材料在工业领域的应用。生物降解塑料以淀粉,纤维素等可再生资源为原料,经完全无污染工艺生产100%全降解生物树脂原料和成型塑料制品。这是当前世界上最顶尖的生物降解技术,最佳的石油泡沫塑料替代品。
主要产品:淀粉、纤维素制可降解塑料
应用领域:餐饮、包装等。
52、广州金发科技股份有限公司
金发科技是全球领先的新材料企业,依托高性能新材料的科研、生产、销售和服务,旗下拥有30多家子(孙)公司,在南亚、北美、欧洲等海外地区设有办事机构。金发科技的产品以自主创新开发为主,覆盖了改性塑料、特种工程塑料、精细化工材料、完全生物降解塑料、木塑材料、碳纤维及其复合材料等自主知识产权产品。金发科技材料以其良好的环境友好度和卓越的性能远销全球130多个国家和地区,为全球1000多家知名企业提供服务。
主要产品:生物基尼龙、可降解材料等。
应用领域:塑料袋、食品包装、纺织服装等。
53、济南圣泉集团股份有限公司
济南圣泉集团股份有限公司始建于1979年,现有员工3600人,总资产60亿元,是一家专注于各类植物秸秆的研究、开发与综合利用,涉足树脂及新材料、大健康、生物质和生物医药四大产业的创新型企业集团。经过30多年创新可持续发展,公司在植物秸秆的研发和综合利用方面走出了一条对全球有示范意义的成功道路,成为全球生物质能源和生物质新材料产业的引领者,入选了中国民营企业制造业500强。
主要产品:新一代呋喃树脂、纤维素乙醇、高弹力植物纤维、糠醛、木糖、高活性木质素、高性能木质素染料分散剂、生物基炭材料、生物碳、活性炭等。
应用领域:汽车、机床、船舶、飞机,风电、通用机械、精密仪器等。
54、山东兰典生物科技股份有限公司
山东兰典生物科技股份有限公司成立于2012年,注册资金1.1亿元,公司位于山东省寿光市羊口高新技术产业园区内,公司“以非粮原料生物法50万吨/年琥珀酸及生物基产品PBS产业化项目”分三期建设,配置丁二酸发酵系统、分离提取系统、酯化加氢制丁二醇系统、PBS聚合系统以及自备电厂、污水处理厂、综合办公、生活区等共占地面积1500亩,主要产品有琥珀酸、1,4-丁二醇、聚琥珀酸丁二醇酯(PBS)等。项目的总资金55.8亿元。项目总投资50.2亿元,
主要产品:琥珀酸、1,4-丁二醇(BDO)、聚琥珀酸丁二醇酯(PBS)。
应用领域:表面活性剂、清洁剂、添加剂、起泡剂、医药等。
55、上海美东生物材料股份有限公司
上海美东生物材料股份有限公司是一家基于腰果壳油研究、开发、应用,从事精细环氧树脂固化剂系列产品研发、生产、销售的高科技企业,是全球极少数从事腰果壳油系列化工产品应用研究和批量生产的企业之一,是国内行业龙头。
主要产品:腰果壳油环氧树脂固化剂、稀释剂、表面活性剂(聚氧乙烯醚)、环氧树脂、腰果酚、腰果油以及摩擦粉等。
应用领域:海洋船舶、航空航天、邮电通讯、建筑桥梁、钢架结构、储罐管道等。
56、山东吉青化工有限公司
山东吉青化工有限公司成立于2005年,总投资12亿元,拥有生产车间6万平方米,自动化生产线4条,国内外原材料生产基地3处,年设计产能30万吨,是一家专业从事生物基材料研发与生产的国家备案高新技术企业,是中国国家生物化工与生物质能源联合会副理事长单位,中国工业生物材料产业技术创新战略联盟理事长单位。公司自主研发的生物基增塑剂经谱尼、SGS等权威机构检测,关键性指标超过国际同类产品,居世界领先水平,已成为国际公认的可100%替代传统邻苯类增塑剂的绿色环保产品。
主要产品:生物基增塑剂
应用领域:塑料改性
57、潍坊华潍膨润土集团股份有限公司
潍坊华潍膨润土集团股份有限公司是集科研、开发、生产于一体的国家级重点高新技术企业,先后荣获中国专利山东明星企业、省级守合同重信用企业、低碳山东示范单位、山东著名商标等荣誉。组建了膨润土工程研发中心和降解复合材料企业重点实验室,建立了青岛科技大学降解材料产学研基地。经营范围涵盖矿产、膨润土、BMSC复合环保材料、生物酶菌、金融服务等多个领域。下设山东华潍膨润土有限公司、潍坊华潍新材料科技有限公司、朝阳华潍膨润土科技有限公司等多家子公司。
主要产品:淀粉膨润土复合生物降解颗粒等。
应用领域:塑料包装、油漆涂料等。
58、广州碧嘉材料科技有限公司
广州碧嘉材料科技有限公司专业从事聚乳酸(PLA)改性及应用研发和生产。公司在提升聚乳酸性能方面取得了巨大的成就,尤其是在提高耐热性和增韧等方面。碧嘉公司作为集研发、生产、销售为一体的高科技企业,具备强大的研发实力。公司不仅配置了最先进的研发设备,更集中了国内外近二十名科技精英。
主要产品:各种改性聚乳酸、吹膜级生物降解塑料等。
应用领域:纺织服装、生物医药、胶黏剂、一次性用品、汽车等。
59、湖南海纳百川生物工程有限公司
湖南海纳百川生物工程有限公司原名益阳海纳百川科技有限公司,是湖南省高新技术企业,是国家863项目----酶法生产生物柴油及国家“十五”科技攻关项目----发酵法生产1,3-丙二醇项目产业化示范基地。2006年8月公司正式通过中国质量认证中心的认证,取得ISO9001质量体系认证证书。公司2002年7月成立,公司主要从事生物酶制剂、生物能源、生物基化学品的研究、开发和生产。
主要产品:生物柴油、甘油、植物沥青、1,3-丙二醇
60、浙江嘉利蛋白纤维有限公司
浙江嘉利蛋白纤维有限公司由浙江展望控股集团有限公司全资建立,运用我国原创高新技术,专业生产大豆蛋白功能纤维的规模型生产企业,公司总投资3.6亿元人民币,占地面积300亩,建设12条自动化生产线,年产大豆蛋白功能纤维18000吨。首期年产9000吨纤维生产线於2003年10月投产。
主要产品:
1、纤维:棉型纤维 1.5D 3D 38mm 51mm 毛型纤维 1.5D 3D 76mm 102mm
2、纱线:100%大豆纤维纱线,豆/棉混纺纱线,豆/棉/绒混纺纱线,其它可按客户需要订纺。
3、成衣:主要为针织内衣,现已和国内著名内衣品牌合作。
4、其他:大豆短裤、大豆袜子、大豆毛毯。
应用领域:纺织服装
61、常茂生物化学工程股份有限公司
常茂生物化学工程股份有限公司成立于1992年底,是江苏省高新技术企业,江苏省外商投资先进技术企业和双密集型(技术密集型和知识密集型)企业1998年通过了ISO9002质量管理体系认证,2003年通过了ISO9001改版认证,2005年通过HACCP认证,2002年6月于香港创业板挂牌上市。公司综合运用生物技术,精细化工技术和手性技术,专业生产,销售四碳系列高品质有机酸和手性产品,是目前世界上独具特色的四碳系列有机酸制造商。
公司产品:L-苹果酸、DL-苹果酸、L(+)-酒石酸、L-天冬氨酸、富马酸、马来酸等有机酸
应用领域:食品、医药
62、安庆和兴化工有限责任公司
安庆和兴化工有限责任公司位于安徽省安庆市经济技术开发区1.3平方公里工业园内,是国家高新技术企业,也是目前国内专业从事丁二酸及丁二酸二钠等产品生产和出口企业。公司主要生产丁二酸、丁二酸二钠、丁二酰亚胺、PBS等精细化学品,产品质量上乘,工艺先进,获国家发明专利二项,国家实用新型专利三项,安徽省高新技术产品一项,丁二酸二钠获安徽省高新技术产品一项。为了迅速扩张国际市场,公司产品于2002年3月部分通过犹太洁食认证(DOSHER CERTIFICATE)。
主要产品:PBS母粒、片材、薄膜、一次性餐具等。
应用领域:餐饮包装
63、金晖兆隆高新科技有限公司
山西金晖集团顺应时代发展于2012年在山西省孝义经济开发区全资组建了金晖兆隆高新科技有限公司,建成20000吨/年生物降解聚酯原料、10000吨/年生物降解聚酯改性料、10000吨/年丁二酸生产基地。金晖兆隆先后推出爱柯沃得(Ecoworld)生物降解聚酯改性原料品牌和爱柯维尔(Ecowill)生物降解聚酯改性料品牌,同时在长春和孝义分别设有两个生物降解聚酯改性料基地。
主要产品:生物降解聚酯改性原料和PLA、生物降解聚酯改性原料和淀粉的改性料。
应用领域:一次性水杯、餐具、购物袋等。
64、新疆蓝山屯河化工股份有限公司
新疆蓝山屯河化工股份有限公司是一家依托新疆资源优势成长壮大的高科技化工新材料企业,是国有控股的中外合资股份制企业。公司下辖聚酯、型材、新材料、能源等四家全资子公司,具有世界先进的生产装备和领先的工艺技术,获得了GB/T19001-2008质量管理体系;GB/T24001-2014环境管理体系;GB/T28001-2011职业健康安全管理体系认证。公司是国家认定的高新技术企业、国家创新型试点企业和自治区百户“优强企业”之一,拥有国家级博士后科研工作站、国家级企业技术中心,以及优秀的管理团队和深厚的企业文化,荣获了174项国家专利,三个新疆名牌产品称号。主要产品PBT、EPS、PET、PBS、PVC型材等综合生产能力达52万吨/年,主导产品填补了西北化工产业空白。
主要产品: PET树脂、PBT树脂、PBS完全生物降解树脂、四氢呋喃(THF)等。
应用领域:一次性餐具、快速消费品包装等。
65、山东合敬生物基材料有限公司
主要产品:主营植物纤维环保花盆、植物纤维环保餐具、植物纤维环保建材、植物秸杆花盆、植物秸杆筷子、植物秸杆餐具、植物秸杆建材、生鲜托盘、育苗杯、插花筒、干果托盘及生产设备的销售。
应用领域:花盆、餐具等。
66、杭州曦茂新材料科技有限公司
杭州曦茂新材料科技有限公司成立于2010年5月,是由海外留学技术专家组成核心团队,汇集了国内外多位资深的高分子材料、生物工程、有机合成、机械设计与制造等领域的专家和科技人才,主要从事高端精细化学品和生物高分子材料的技术研究开发、产业化应用,并提供一站式解决方案的专业化公司。
曦茂科技产品涵盖高纯有机试剂、无机试剂、生化试剂、耐热结晶成核剂、环氧官能化扩链剂、纳米高分子刷反应性相容剂、生物基高效增塑剂、有机抗水解稳定剂、环保无卤透明阻燃剂、透明结晶成核剂、光稳定扩散剂、生物合成有机催化剂、超精细纳米高分子材料等。
主要产品:聚乳酸树脂、淀粉基全生物降解母粒、各种助剂等。
应用领域:发泡材料、薄膜、奶瓶等。
67、安徽雪郎生物科技股份有限公司
安徽雪郎生物科技股份有限公司是一家以研发、生产、销售功能性食品添加剂和生物降解新材料的股份制高新技术企业。公司未来几年将形成3 + 1的产业布局,即建成一个绿色化工生产技术平台--年产5万吨顺酐基础原料及能源供应平台;
功能添加剂产业:建成2.0万吨/年DL-苹果酸,5000吨/年生物基L-苹果酸(国家863重大项目产业化工程),5000吨/年L-天门冬氨酸及聚合物, 10000吨/年富马酸;
生物降解新材料产业:建设2万吨/年全生物降解塑料系列(PBS)的生物降解环保新材料产业化示范基地;
功能性终端产品:苹果酸系列功能性健康产品。
规划实现后可使年销售收入达10亿元以上,成为世界苹果酸系列产品的主要生产基地和生物降解环保新材料产业化示范基地。
主要产品:DL-苹果酸、L-苹果酸、L-天门冬氨酸及聚合物、PBS等。
68、宁波吉丰环保科技发展有限公司
主要产品:全降解包装材料等。
应用领域:运输包装等。
69、宁波云升新材料有限公司
宁波云升新材料有限公司成立于2004年8月,现已有塑料改性车间、生物降解车间、塑料制品加工车间以及多功能研发车间等多个车间,公司产品全部通过SGS认证,并曾获得了“市级高新技术产品”、“科技进步奖”、“高新技术转化项目奖”和拼装式塑胶地板获得的“外观设计专利证书”等殊荣,2006年度公司通过了“中国环境标志”认证,2009年通过ISO9001质量体系认证。
主要产品:光--生物双降解塑料母料、降解焚烧符合环保母料和制品、各类改性填充母料、筹码料、阻燃母料、色母粒、管道料、抗静电母料、阻燃母料以及其他的改性功能母料及悬浮式拼装运动地板制品。
应用领域:餐饮、塑料袋等。
70、山东寿光巨能金玉米开发有限公司
山东寿光巨能金玉米开发有限公司成立于1998年3月,是以农产品(玉米)深加工为主导,生产经营玉米淀粉、变性淀粉、氨基酸、淀粉糖、乳酸、聚乳酸和生物质热塑复合材料的综合大型企业公司,2007年9月27日在香港联交所上市。
公司现有寿光和临清两大生产基地,下设临清德能金玉米生物有限公司和寿光金远东变性淀粉有限公司。金玉米公司是山东省农业产业化重点龙头企业、省级重合同守信用企业、省级企业技术中心、山东省信息化示范企业、食品卫生A级企业、标准化良好行为企业,公司先后通过ISO9001质量管理体系认证、ISO22000食品安全管理体系认证、ISO14001环境管理体系认证、OHSAS18001职业健康安全管理体系认证、IP(非转基因)认证、FAMI-QS认证(欧洲饲料添加剂与预混合饲料质量体系)等,是全省第一家获得食品级淀粉生产许可证的企业。2005年圣玉牌玉米淀粉被评为“中国名牌”称号,产品质量处于国内顶尖水平。
主要产品:玉米淀粉、变性淀粉、氨基酸、淀粉糖、乳酸、聚乳酸和生物质热塑复合材料。
71、金丹生物新材料有限公司
河南金丹乳酸科技股份有限公司是一家以玉米为原料,采用微生物发酵技术生产乳酸的国家级高新技术企业,河南省百户重点工业企业,国家循环经济试点企业,国家农业产业化龙头企业。生产规模居亚洲第一位,世界第二位,产品销售世界五十多个国家和地区,属典型的农产品深加工外向型企业。
主要产品:乳酸、多种乳酸盐、乳酸脂类。
72、内蒙古东源科技有限公司
内蒙古东源科技有限公司成立于2008年12月,注册资本2亿元,由内蒙古中远亨峰能源化工有限公司全资控股。公司引进美国英威达先进技术,利用炔醛法生产1,4-丁二醇。同时,围绕1,4-丁二醇为核心项目,延伸产业链,实现上、中、下游产品链全面配套,根据公司的长远战略规划,公司将投资建设以1,4丁二醇为主体的一体化项目和以光热项目为主体的一体化项目,总体项目建成后,总投资达到238.89亿元,实现总产值275.7亿元,本项目填补了内蒙古自治区化工产业空白,已被列入自治区重点化工建设项目。
主要产品:1,4-丁二醇等。
73、万华化学集团股份有限公司
万华化学集团股份有限公司主要从事异氰酸酯、多元醇等聚氨酯全系列产品、丙烯酸及酯等石化产品、水性涂料等功能性材料、特种化学品的研发、生产和销售,是全球最具竞争力的MDI制造商之一,欧洲最大的TDI供应商。万华化学是中国唯一一家拥有MDI制造技术自主知识产权的企业,产品质量和单位消耗均达到国际先进水平。
自2005年国际化战略布局开始,万华化学已初步搭建了国际化雏形,在国内,烟台、宁波、北京、珠海、成都、上海等地的研发、生产基地和商务中心已逐渐成型;在国外,美国、日本、印度等十余个国家和地区均设有法人公司和办事处。2011年,万华化学托管匈牙利BC公司,标志着万华化学的国际化进程又迈出了里程碑式的一步。
主要产品:多元醇、异氰酸酯等聚氨酯全系列产品,丙烯酸及酯等。
74、长春大成实业集团有限公司
大成生化科技集团有限公司始建于1994年。经过二十年的拼搏奋斗,逐步发展为以生物发酵技术、生物化工技术为主的玉米精深加工企业,是首批国家级农业产业化龙头企业。现已发展为横跨玉米淀粉、淀粉糖、氨基酸和生物化工醇等多种产业的集团公司。
目前,集团拥有员工近7000人,分别在吉林省长春、德惠、兴隆山、辽宁省锦州、黑龙江省哈尔滨、上海等地区设有生产基地。科研方面,集团拥有1个设计研究院,4个研究所,6个产品工业园区。
主要产品:玉米淀粉、淀粉糖、氨基酸和生物化工醇等。
75、杭州鑫富科技有限公司
杭州鑫富科技有限公司是一家高科技上市公司,是世界最大的维生素B5生产供应商,国内唯一的维生素原B5生产企业。在临安、湖州、安庆、重庆等拥有5个分子公司,员工1600余人,总资产10多亿元,重点发展化工(生物化工、精细化工)、全生物降解新材料、环保新材料等支柱产业,产品70%销往欧美国家和东南亚地区。Biocosafe生物分解树脂以二元酸与二元醇为原料,采用高效无毒催化剂,按一步缩聚法直接合成。
主要产品:全生物降解新材料
76、九江科院生物化工有限公司
九江科院生物化工有限公司,位于江西省九江市,注册资本11800万元,致力于环境友好生物基材料产业发展,是高性能聚乳酸材料及其单体的制造商。公司自主拥有国际领先的非粮生物质-乳酸-聚乳酸绿色产业链的核心技术,于2015年底成功引入战略投资者,启动产业化建设,首期工程为1000吨/年高性能聚乳酸及其单体生产线及万吨级聚乳酸基础设施的建设。
主要产品:聚乳酸、乳酸、纤维素酶、秸秆糖、竹纤维
应用领域:医药、包装、服装、无纺布、电子电器零部件、汽车部件等,可用于挤出、注塑、吹膜、纺丝等。
77、浙江旭日纤维有限公司
浙江旭日纤维有限公司始创于1990年,是一家集研发、生产、销售于一体的高新技术企业。旭日纤维凭借多年从事化纤行业的经验与深厚的专业技术,并响应国家节能减排2003年自主研发FDY丙纶长丝,同时引进德国日本等多家国外的纺丝技术,对原国内厂家采用的二步纺技术起到了更新换代的作用,使公司在市场竞争中取得长足的进步。
主要产品:玉米纤维、聚乳酸生物质纤维、生物基聚乳酸(PHBV)面料等。
应用领域:纺织服装
78、博大东方新型化工(吉林)有限公司
主要产品:二氧化碳聚合物(PPC)
应用领域:农用地膜等。
79、上海同化新材料科技有限公司
同化新材料(Tonnor Material Science)是由同济大学博士、硕士研究生创办的高科技企业,一直得到科技部、教育部和上海市政府的重点支持。公司专注于生物质材料领域,在有机纤维方面拥有核心竞争力。同化团队不断用创新的“有机环保新材料”为客户和环境带来新的改变。 Viscel、Elegcel、Filucel和Hylicel等多个纤维产品在食品、医药、化学增强、有机助滤等领域具有创新应用。
主要产品:FILUCEL、ELEGCEL、VISCEL、HYLICEL纤维
应用领域:塑料、橡胶、电木粉、轮胎、合成革等高分子增强领域、热塑性树脂、工程塑料、尼龙、沥青等高温加工领域等。
80、恒天宝丽丝生物基纤维股份有限公司
恒天宝丽丝生物基纤维股份有限公司成立于2015年7月,是以研发、生产和销售再生纤维素生物基复合纱线为核心业务,集纺纱,捻线,染整,制线于一体的行业领军型企业。
公司主营再生纤维素生物基长丝,生物基长丝复合纱线、生物基短纤复合纱线、高档绣花线、高强涤纶缝纫线、高强尼龙缝纫线。公司拥有各类长丝、短丝倍捻机、复合机,月生产能力为300吨。作为染整生物基纤维精加工基地,拥有筒子缸、喷缸两条染色生产线,筒子染色月生产120吨,绞纱染色月生产180吨。
主要产品:再生纤维素生物基长丝,生物基长丝复合纱线、生物基短纤复合纱线、高档绣花线、高强涤纶缝纫线、高强尼龙缝纫线
应用领域:纺织服装
更多关于材料方面、材料腐蚀控制、材料科普等方面的国内外最新动态,我们网站会不断更新。希望大家一直关注中国腐蚀与防护网http://www.ecorr.org
责任编辑:王元
投稿联系:编辑部
电话:010-62313558-806
中国腐蚀与防护网官方 QQ群:140808414
免责声明:本网站所转载的文字、图片与视频资料版权归原创作者所有,如果涉及侵权,请第一时间联系本网删除。

官方微信
《腐蚀与防护网电子期刊》征订启事
- 投稿联系:编辑部
- 电话:010-62316606
- 邮箱:fsfhzy666@163.com
- 腐蚀与防护网官方QQ群:140808415





